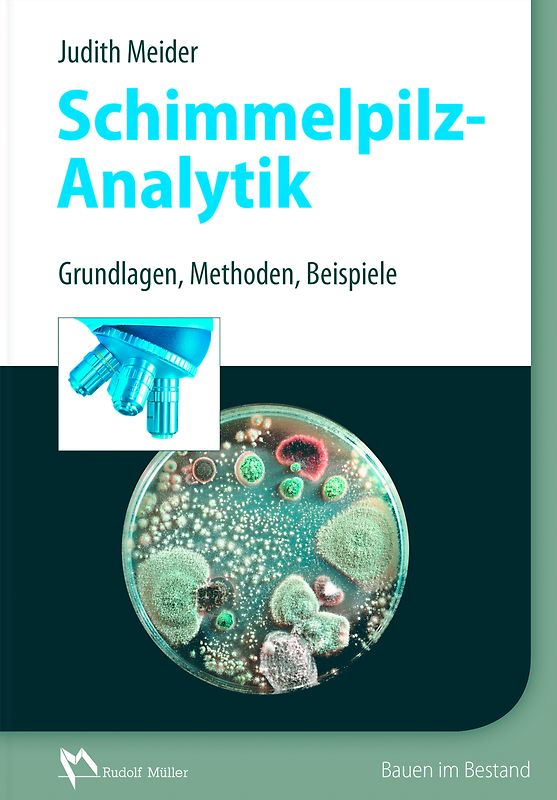
Schimmelpilzanalytik

Handgeprüfte Gebrauchtware
Bis zu 50 % günstiger als neu
Der Umwelt zuliebe
oder
Du kannst wie immer einen Kaufalarm setzen, wenn du auf das gebrauchte Buch warten möchtest.
Handgeprüfte Gebrauchtware
Bis zu 50 % günstiger als neu
Der Umwelt zuliebe
Hersteller: Müller Rudolf, Stolbergerstr. 84, Köln, Deutschland, 50933, herstellung@rudolf-mueller.de, herstellung@rudolf-mueller.de
